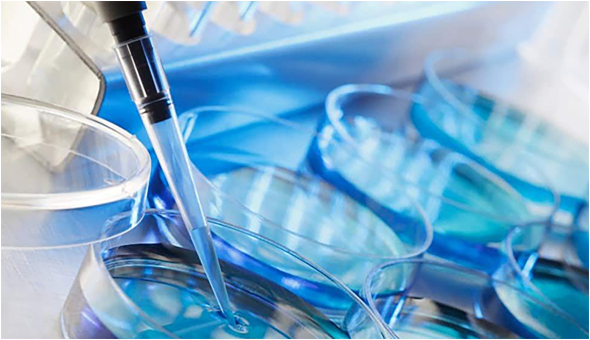

Industry Trends
INDUSTRY
Take food safety as your own responsibility changing food safety and health